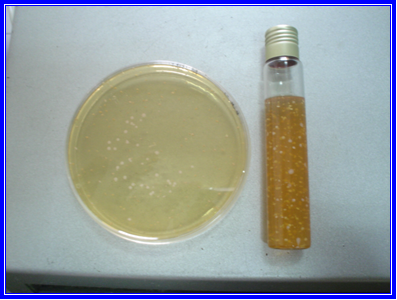
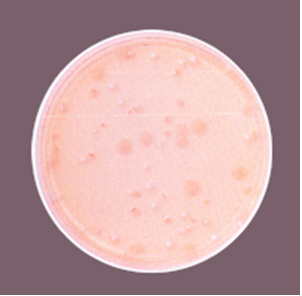

MRS AGAR (Lactobacillus)
Medio selectivo para el aislamiento y recuento de Lactobacillus en productos lácteos, cárnicos y otros alimentos
Formulado según Man, Rogosa y Sharpe (ISO 9232:1999, ISO 15214:1998)
La siembra en masa en tubo de MRS Agar es mucho más sensible que la siembra en masa en placa, ya que en él las diferentes concentraciones del nivel de oxígeno permiten una muy mejor recuperación de todo tipo de cepas de lactobacilos.
DESCRIPCIÓN GENERAL
El MRS Agar es un medio selectivo diseñado para el aislamiento, enumeración y cultivo de bacterias del género Lactobacillus y otros microorganismos ácido-lácticos (BAL) presentes en lácteos, productos cárnicos, bebidas fermentadas, y muestras clínicas o ambientales.
Desarrollado por Man, Rogosa y Sharpe, y reconocido por normas internacionales (ISO 9232 e ISO 15214), este medio ofrece una excelente recuperación de cepas lácticas, incluso las más exigentes, como L. brevis o L. fermentum.
COMPOSICIÓN (por litro)
| Componente | Cantidad |
|---|---|
| Peptona de carne | 10,0 g |
| Extracto de carne de buey | 8,0 g |
| Extracto de levadura | 5,0 g |
| Glucosa | 20,0 g |
| Fosfato dipotásico | 2,0 g |
| Acetato de sodio | 5,0 g |
| Citrato triamonio | 2,0 g |
| Sulfato de magnesio | 0,2 g |
| Sulfato de manganeso | 0,05 g |
| Tween 80 (polisorbato) | 1,0 g |
| Agar-agar | 10,0 g |
pH final: 6,4 ± 0,2
PREPARACIÓN
-
Disolver 63 g de medio en 1 litro de agua bidestilada.
-
Calentar con agitación hasta ebullición para su completa disolución.
-
Autoclavar a 121 ºC durante 15 minutos.
-
Dejar enfriar antes de verter en placas o tubos.
Nota: Formulado según Man, Rogosa y Sharpe, el MRS Agar es ideal para el aislamiento de lactobacilos provenientes de alimentos y muestras biológicas, incluidos L. brevis, L. fermentum, L. plantarum y L. lactis.
Para uso exclusivo en laboratorio.
Agite el bote antes de usar.
Mantenga el bote bien cerrado en lugar seco, fresco y oscuro.
Código: DMT080
CONTROL DE CALIDAD DEL MEDIO
El control se realiza en nuestro laboratorio. Se recomienda repetirlo si cambian las condiciones de almacenamiento (más de 3 meses sin uso, tras desinfección del laboratorio o exposición a alta temperatura).
Aspecto:
-
Deshidratado: Polvo fino, color tostado.
-
Preparado: Medio estéril, color ámbar.
EVALUACIÓN DEL RENDIMIENTO (ISO/TS 11133-2)
Incubación: 72 h a 30 ºC en microaerofilia (siembra en masa o tubo profundo).
Métodos aplicables: ISO 9232:1999, ISO 15214:1998, o el Manual MICROKIT actualizado.
| Microorganismo | Resultado esperado | Productividad relativa (PR) | Observaciones |
|---|---|---|---|
| Lactobacillus plantarum MKTA 8014 | Excelente | >0,5 | Recuento 62–99 % respecto a PCA estandarizado*. |
| Lactobacillus lactis MKTA 19435 | Excelente | >0,5 | Recuento >50–120 %. |
| Pediococcus damnosus MKTA 29358 | Excelente | >0,5 | Recuento >50–100 %. |
| Escherichia coli MKTA 25922 | Inhibido | — | Sin crecimiento. |
| Bacillus cereus MKTA 11778 | Inhibido | — | Sin crecimiento. |
| Staphylococcus aureus MKTA 6538P | Débil o inhibido | — | Crecimiento escaso o nulo. |
* PCA estandarizado con recuperación ≥ 92–125 % respecto a cepas trazables a la colección tipo.
SIEMBRA Y CONDICIONES DE INCUBACIÓN
Método recomendado: Siembra en profundidad con doble capa.
-
Sembrar 1 ml de muestra o dilución decimal en placa Petri.
-
Añadir 15 ml de MRS fundido, dejar solidificar.
-
Añadir 5 ml adicionales y dejar solidificar de nuevo.
-
Incubar a 30 ºC durante 5 días o 37 ºC durante 3 días, preferentemente en atmósfera de microaerofilia.
La siembra en tubo en profundidad ofrece mayor sensibilidad que la siembra en placa, al generar un gradiente de oxígeno que favorece la recuperación de cepas microaerófilas y anaerobias facultativas.
INTERPRETACIÓN DE RESULTADOS
-
Contar las colonias características de Lactobacillus.
-
También pueden crecer Leuconostoc mesenteroides y L. dextranicum (presuntos lactobacilos).
-
Confirmar mediante pruebas bioquímicas (KUS801).
Cepas típicamente recuperadas:
L. helveticus, L. jugurti, L. bulgaricus, L. lactis, L. acidophilus, L. leichmanii, L. delbrueckii, L. salivarius, L. brevis, L. fermentum, entre otros.
NOTAS Y VARIANTES RECOMENDADAS
-
Para un crecimiento más rápido y exuberante, utilizar Tomato Juice Agar.
-
Para distinguir bacterias ácido-lácticas de aerobios, usar el medio cromogénico CROMOKIT-LAC (MRS Agar cromogénico), donde las colonias lácticas se observan verdes.
PRESENTACIÓN
Medio deshidratado.
GESTIÓN DE RESIDUOS
El usuario final es responsable de la eliminación de los microorganismos según la legislación medioambiental vigente.
Autoclavar los residuos antes de desecharlos.
INFORMACIÓN ADICIONAL
Ficha técnica MRS Agar (PDF)
Ver también: Cromokit Lactobacillus Agar (medio cromogénico)
Correo: microkit@microkit.es
Teléfono: 91 897 46 16

Buenas tardes, me interesa saber los costos de este medio de cultivo. Muchas gracias!!
Buenos días
Respondemos a su consulta desde nuestro correo general.
Muchas gracias por visitar nuestro blog y contactar con nosotros. Un cordial saludo
hola presio de este tipo de agar mrs
Buenos días
Respondemos a su consulta desde nuestro correo general.
Muchas gracias por visitar nuestro blog y contactar con nosotros. Un cordial saludo
Cuanto es el costo del medio de cultivo
Buenos días
Respondemos a su consulta desde nuestro correo general.
Muchas gracias por visitar nuestro blog y contactar con nosotros. Un cordial saludo
Buenos días,
Me interesa saber el costo de este medio de cultivo por favor.
Buenos días
Respondemos a su consulta desde nuestro correo general.
Muchas gracias por visitar nuestro blog y contactar con nosotros. Un cordial saludo
Buenas tardes, me interesa saber los costos de este medio de cultivo. Muchas gracias!!
Buenos días
Respondemos a su consulta desde nuestro correo general.
Muchas gracias por visitar nuestro blog y contactar con nosotros. Un cordial saludo
Buenos dias:
Por este medio solicito información de las pruebas bioquímicas (KUS801) que mencionan para la identificación de lactobacilos.
Agradeceré mucho dicha información.
Saludos cordiales
Buenos días,
Respondemos su consulta desde nuestro correo general. Muchas gracias por visitar nuestro blog y contactar con nosotros.
Un cordial saludo.
Buenas tardes necesito saber el precio del agar MRS para lactobacillus gracias
Buenos días,
Respondemos su consulta desde nuestro correo general. Muchas gracias por visitar nuestro blog y contactar con nosotros.
Un cordial saludo
Holaa
Cuanto esta el precio de agar mrs?
Hola, puedes consultarlo en microkit@microkit.es